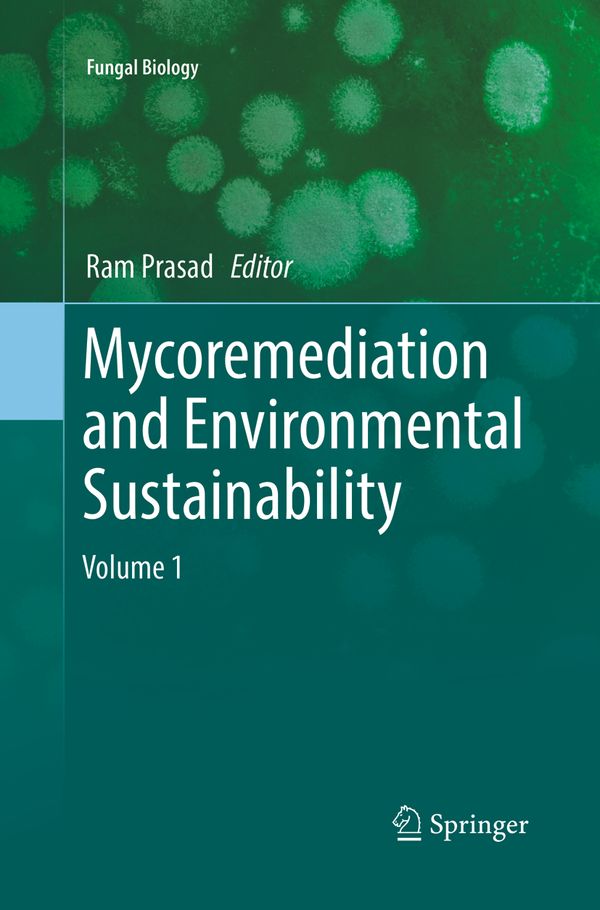
Mycoremediation and Environmental Sustainability | 1:a upplagan

Vi flyttar från butik till nätet - så funkar det framåt
Mycoremediation and Environmental Sustainability | 1:a upplagan
- Häftad, Engelska, 2019
- Författare: Ram Prasad
- Betyg:
Skickas inom 1-3 vardagar
Vill du sälja den här boken?
Sälj den här bokenBeskrivning
Om denna bok
Mycoremediation and Environmental Sustainability av Ram Prasad är en Häftad bok med 240 sidor på Engelska. Detta är den 1:a upplagan som utgavs 2019 av Springer Nature.
Spara pengar – köp begagnad från Campusbokhandeln
Köp Mycoremediation and Environmental Sustainability begagnad från Campusbokhandeln och spara upp till 25% jämfört med nypris. Du kan bevaka den här boken så får du ett mail så fort vi får in den i lager som begagnad.
Genom att köpa & sälja begagnat sänker du kostnaden för studier både för dig och nästa student samtidigt som du gör nytta för klimatet.
Produktinformation